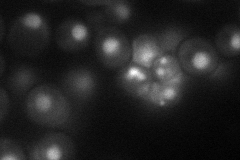
YDR195W
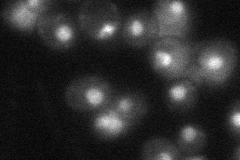
YDR195W
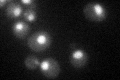
YDR195W

View description
RNA-binding protein involved in the cleavage step of mRNA 3'-end formation prior to polyadenylation, and in snoRNA maturation; part of holo-CPF subcomplex APT, which associates with 3'-ends of snoRNA- and mRNA-encoding genes
Localization:
Intensity:
Fold change:
Significance:
-
C’ GFP library in SD

nucleus35.75 -
N' NOP1pr-GFP in SD
nucleus37.7217 -
N' TEF2pr-mCherry in SD

nucleus13.8432 -
N' NATIVEpr-GFP in SD
nucleus37.3879 -
N' TEF2pr-VC and Cyto-VN in SD

below threshold24.3408 -
C’ GFP library in SD+DTT

nucleus36.051No -
C’ GFP library in SD+H2O2
nucleus37.961.06No -
C’ GFP library in Starvation Media

nucleus33.130.92No -
C’ GFP library on the background of Pup2-DaMP

nucleus -
C’ GFP library on the background of CCT mutant

nucleus37.84461.05852No
